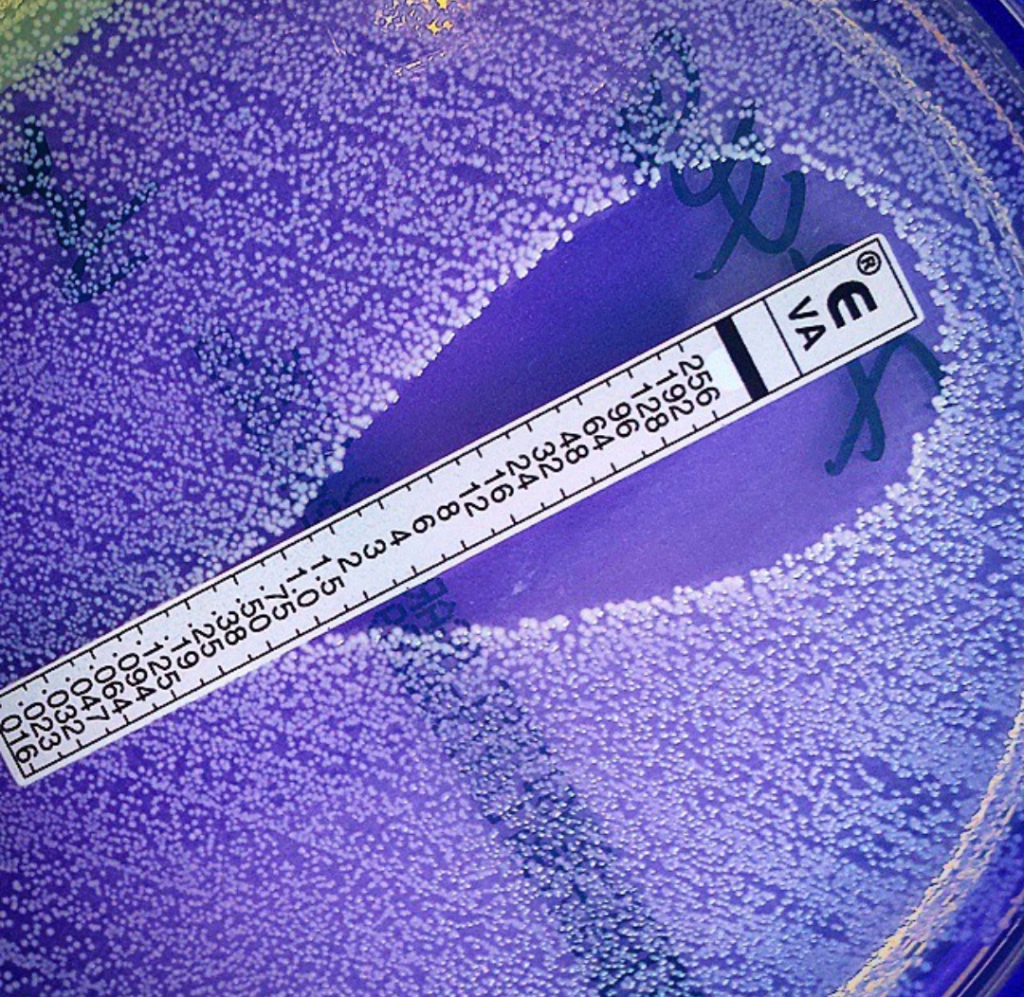

I’ve been talking to quite a lot of people about antimicrobial resistance lately. Partly because I’m involved in a big clinical trial called LAKANA, but also because I’ve been recording some content for the Department of Education and school teachers linked to Infection Prevention and Control. What has struck me is that something that has such a massive day to day impact on my working life hasn’t really made its way into the public consciousness just yet.
As last week was antimicrobial awareness week, I thought I should take the opportunity to talk about antimicrobial resistance and why I think we should be working hard to talk about it more: in the pub with our friends, with our families over Christmas, and with our patients and students.
What Is Antimicrobial Resistance?
When I go into classrooms and speak to members of the public they sometimes think that antimicrobial resistance is when our bodies become ‘immune’ to antibiotics. This isn’t the case. When we talk about antimicrobial resistance or, for the rest of this blog post, antibiotic resistance (as I’m talking about bacteria) is when the individual bacteria are not affected by the antibiotic or it works less well (see my introduction to antibiotics post for a bit of background).
Antibiotics work in two main ways. They are either:
- Bacteriostatic = inhibits the growth of bacteria.
- Bactericidal = kills bacteria.
The way the antibiotic works against the bacteria can be linked to the way that the bacteria become resistant to the antibiotic. I’m going to do another blog post with some of the technical details of how this works and how we detect it, so bear with me for a couple of weeks. For this post, the main thing is to know that it is the bacteria that become resistant, not us, and that there are a number of different ways that this can happen:
- Intrinsic resistance = the antibiotic will never work against that particular bacterial species because of the characteristics that species has. This includes things like Vancomycin not working against Gram negative bacteria as the molecule is so large.
- Selective resistance = where a mixed population of resistant and sensitive bacteria are impacted by antibiotic use and the resistant ones survive and therefore become dominant.
- Acquired resistance = where previously sensitive bacteria acquire the ability to resist the effect of an antibiotic, often through acquiring genes, which allow them to change the way they function or replicate.
What has antibiotic resistance got to do with me?

Levels of antibiotic resistant bacteria are being detected in increasing numbers in food (linked to farming), in the environment, and within humans: both in hospitals and in the community. It’s for these reasons (and others) that it has been modelled that more people will die linked to antimicrobial resistance than cancer by 2050. If, as a population, we have more resistant bacteria onboard as part of our normal flora, it is increasingly more difficult to treat us when we need it. It will also become increasingly more difficult to do ‘standard’ surgeries such as hip replacements, tonsillectomies etc. as these require us to give prophylactic antibiotics when you’re in surgery in order to reduce infection risk. This means we may have to live with long-term conditions that currently we would surgically correct.
Most of us think about antibiotics as being something that we either give to really sick people in hospitals or a fairly harmless way to get back to our every day lives when we’re feeling unwell at home. In many ways that is true. Most of us will have had multiple courses of antibiotics during our life and have never given it much thought. Some women may have had the odd bout of thrush when they’ve taken antibiotics for a urinary tract infection and that is the closest they’ve seen to side effects. The case of a woman getting a fungal infection (thrush) because they’ve taken antibiotics that have wiped out the non-harmful colonising bacteria in their vagina is a pretty good example of exactly what can happen in less obvious sites when we take antibiotics. For example, there’s plenty of data that the use of antibiotics can impact on the bacteria in your gut, providing selective pressure and changing what the population of bacteria looks like. Usually this returns to normal over time. However, in a world where the bacteria we encounter are increasingly resistant, that return to normal could take longer; if they got out of the gut to another location due to surgery during that time they could be more difficult to treat.
Colonisation vs Infection
Most of the time if we have resistant bacteria onboard we would never know. They are colonising us, just like our normal bacteria, and not causing us any harm. There’s good data to show now that when we travel abroad to countries with a high prevalence of antibiotic resistant bacteria in food or the environment, that we may exchange some of our sensitive bacteria for resistant ones. You’d never know, especially as when we get home they will usually be replaced again with sensitive versions. However, if you happen to get an infection whilst you have them onboard because you’ve had an accident on holiday, or you’ve travelled for medical care overseas, then the infection may be more difficult to treat.

It’s not just the antibiotics we use in humans that can make this situation worse. Antibiotics are used as growth promoters in farming. We use antibiotics to treat our pets. Because of how expensive and difficult antibiotics are to develop, we are not really developing new ones and so the pool of available antibiotics is getting smaller.
Because antibiotics are used in so many different ways in solving the issue of how to impact levels of antibiotics, resistance is complicated. It requires us to be able to diagnose and detect resistance faster, to work with drug companies in order to tackle the drug development pipeline, and to take a ‘One Health’ approach, looking at farming and veterinary approaches as well human.
So, what can I do?
- Be aware that not all mild respiratory and other conditions require antibiotics. Many are viral and will improve with rest and hydration. Therefore, consider waiting before requesting a prescription for antibiotics.
- If given a prescription, make sure you complete the course. Do not just stop because you start to feel better. Stopping early might mean that you have not completely treated the infection and the remaining bacteria can grow back and sometimes develop resistance.
- Do not buy antibiotics when you are abroad in a country that permits an over-the-counter purchase.
- Do not store antibiotics and use them at a later date. Neither should you use antibiotics that were prescribed for a family member or (and I know people have done this) a pet.
- Think carefully about whether travelling abroad for healthcare is the right choice; make a risk assessment about where you are planning to travel.
If we want to continue to experience healthcare in it’s pre-COVID-19 form, we all need to work together to change the way we use antibiotics so that the modelling predictions do not come true
All opinions on this blog are my own